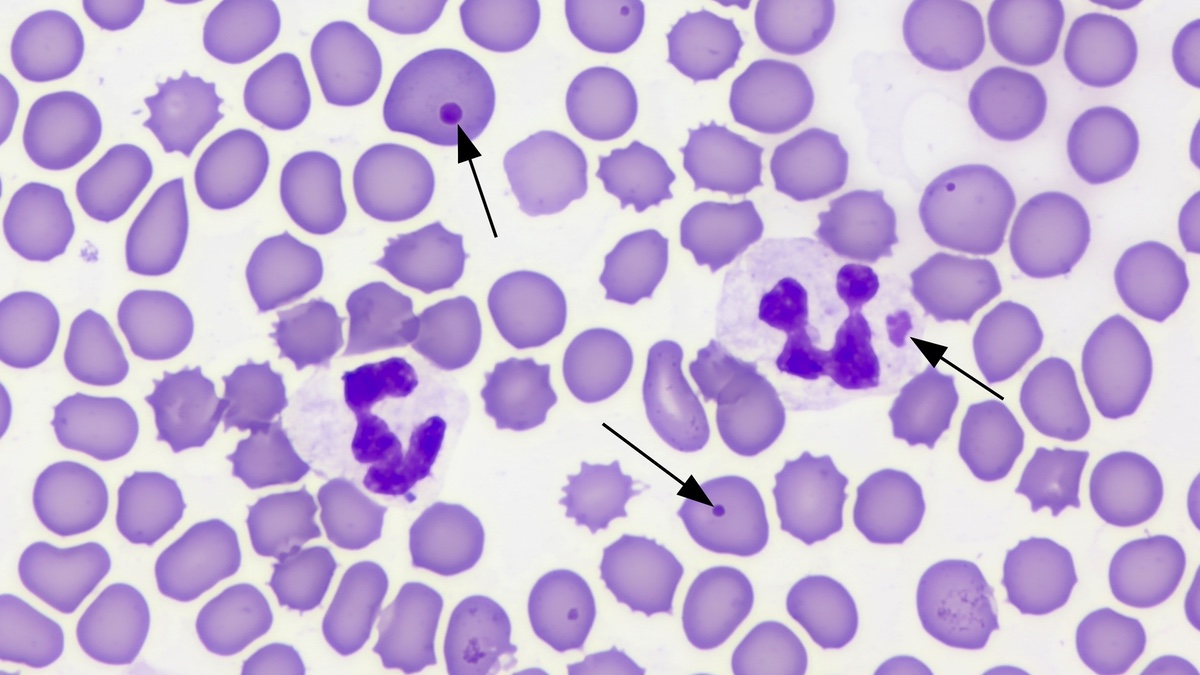
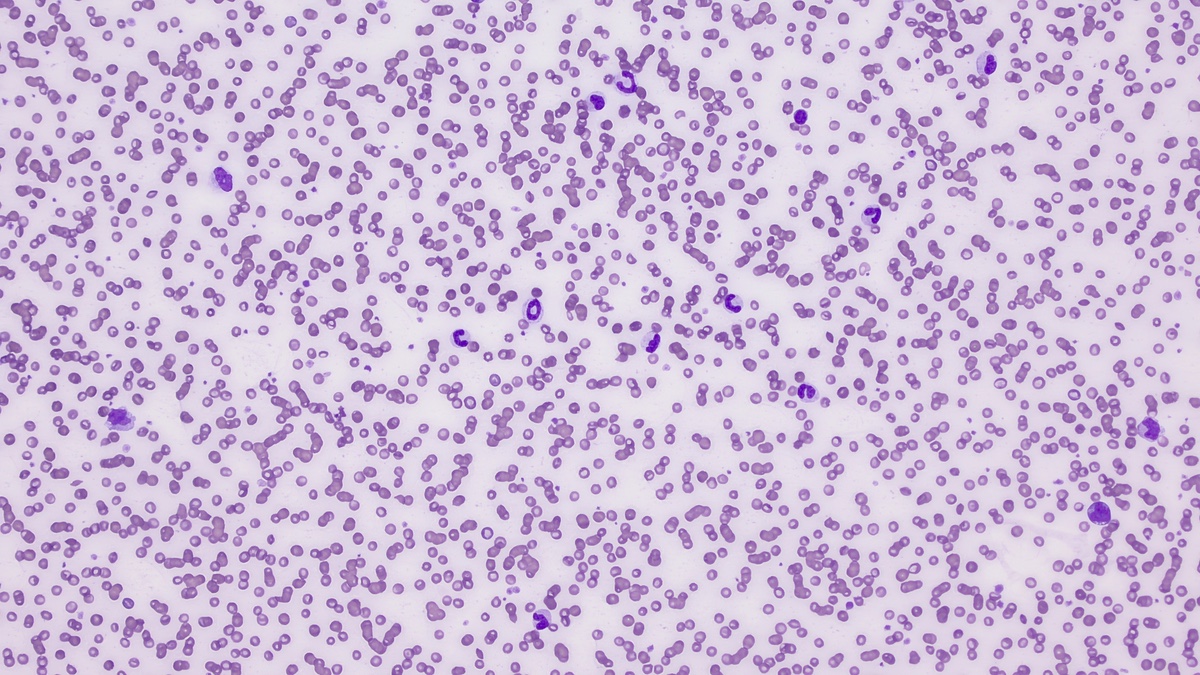

Services
Comprehensive veterinary clinical pathology consulting services
Digital and Glass Slide Cytology and Hematology Interpretation
We are available to interpret a wide variety of cytology or hematology samples, digitally or by glass slides.
- Hematology slides from various species
- Bone marrow aspirate cytology and core histopathology
- Fine needle aspirate cytology
- Fluid cytology (CSF, effusions, etc.)
Clinical Pathology Continuing Education
Whether you and your team are looking to brush up on the basics or if you need a detailed session on a specific topic, we are here to make sure your learning needs are met!
- Lectures (e.g. hematology, cytology, urinalysis, biochemistry interpretation)
- Lecture and lab combination
- Staff training
- Virtual CE or in-person
Interactive Microscope Experience
As we review cases live on the microscope, your team can see it on a screen/projector as well as watch on their iPad. Snap pictures straight from the camera app, annotate and save them for reference!

Laboratory Management and Quality Assurance
In-house analyzers do AMAZING things and allow us to diagnose and treat our patients faster and with incredible convenience. That said, we need to know the limitations of these analyzers and how to ensure accurate results are generated.
- Laboratory protocol development or review
- Quality control and quality assurance
- Staff training

Contract Research Work
Have a study with a Clin Path focus or that requires additional expertise? We are here to help and have previous Good Laboratory Practice (GLP) training/experience!
- Hematology, biochemistry, urinalysis data interpretation (with or without microscopic review)
- Bone marrow aspirate and biopsy review
- Cytology
- Study design
Thank you for your interest in learning more about VCC!
Don't see what you are looking for? Please email us!
Email Us